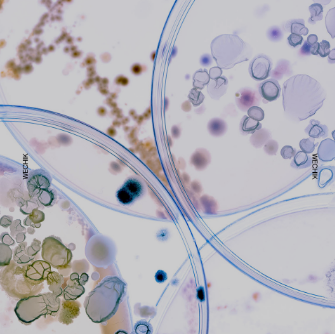

빨래에서 발생하는 세균을 제거하고 효과적으로 빨래를 하는 방법에 대해 설명하겠습니다.
세균의 원인과 영향
빨래에서 발생하는 세균의 원인은 주로 **모락셀라**균입니다. 여름철의 습한 환경에서 이 균이 번식하기 쉬우며, 마르지 않은 빨래에 주로 서식합니다. 이 세균은 세제 찌꺼기, 피지, 담 등을 먹고 산다. 특히 면역력이 떨어진 어린이, 노인 등에게 수막염, 피부염 등이 발생할 수 있으므로 주의가 필요합니다.
세균 제거 방법
1. 베이킹 소다 및 구연산 사용
- **베이킹 소다**를 물에 풀어 빨래를 잠시 담가주거나, 세탁기에 세제와 함께 베이킹 소다를 넣으면 효과적입니다[1].
- **구연산**을 헹굼 과정에 넣어주면 세균을 제거하고 냄새를 없애는 데 도움이 됩니다. 구연산의 산성분이 세균의 번식을 막아주기 때문에 효과적입니다.

2. 식초 사용
- **식초**를 헹굼 과정에 넣어주면 세균을 제거하고 섬유가 부드러워지는 효과도 있습니다. 식초의 시큼한 냄새는 빨래가 마르면서 사라집니다.

3. 건조 시간 단축
- 빨래 건조 시간을 줄이면 모락셀라 균의 번식을 막을 수 있습니다. 빨래한 옷은 세탁 직후 햇볕이 잘 들고 통풍이 잘 되는 곳에서 건조하고, 옷 사이사이에 간격을 넓혀서 말리는 것이 좋습니다. 빨래 사이에 신문지를 끼워 넣거나 내부에 제습기 또는 선풍기를 켜 두는 것도 도움이 됩니다.

4. 세탁기 내부 청소
- 세탁기 내부에서 곰팡이나 세제 찌꺼기가 쌓여서 냄새가 나는 경우가 있습니다. 세탁기 내부를 청소하려면 세탁기에 뜨거운 물을 받아놓고 세탁기 전용 클리너를 넣은 뒤 30분 정도 불린 다음, 세탁 코스를 한 번 돌려주는 것이 좋습니다. 세탁기 내부 청소는 최소 한 달에 한 번씩 하는 것을 추천합니다.

효과적인 빨래 방법
1. **빨래 후 통풍이 잘되는 곳에서 말리기**:
- 빨래 후 옷을 통풍이 잘되고 햇볕이 강한 곳에서 말리면 가장 확실한 방법입니다. 장마철과 같이 날씨가 흐린 날에는 건식 다리미를 이용해 옷을 다리면 옷을 빨리 말릴 수 있고, 섬유 속 세균이 제거되어 냄새가 나는 것도 예방할 수 있습니다.

2. 옷장에 제습제 두기*
- 잘 말린 옷이라도 습한 옷장에 걸어두면 냄새가 날 수 있습니다. 따라서 옷장을 주기적으로 환기해야 하고, 제습제를 두는 것도 좋은 방법입니다. 아울러, 옷을 너무 밀착되게 걸지 말고 간격을 두고 걸어야 공기 순환이 잘 되어 쾨쾨한 냄새가 나지 않습니다.

이 방법들을 적용하면 효과적으로 세균을 제거하고 빨래를 하는 데 도움이 될 것입니다.
